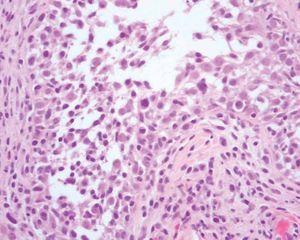

INTRODUCCIÓN
La micosis fungoide es la forma más frecuente de linfoma cutáneo de células T (LCCT)1 . Existen más de 20 subtipos clínicos e histológicos de micosis fungoide, incluyendo formas hipopigmentadas, vesiculosas, pustulosas o granulomatosas2 , entre otras. Sin embargo, estas variantes no se consideran entidades separadas, debido a que por lo general su curso clínico, comportamiento y abordaje terapéutico son similares. Sólo la reticulosis pagetoide y la micosis fungoide folicular se han considerado en la clasificación de la European Organization for Research on the Treatment of Cancer (EORTC)1 y de la Organización Mundial de la Salud (OMS)3 como entidades independientes. La micosis fungoide folicular es una rara variante, caracterizada por la presencia de lesiones foliculares, quistes y comedones característicos, que resultan de la infiltración de los folículos pilosos por las células neoplásicas. La posibilidad de que existan depósitos de mucina foliculares asociados o que su presencia excluya el diagnóstico ha supuesto un motivo de debate en la literatura médica. Se presentan 2 casos de micosis fungoide que clínicamente presentan lesiones foliculares y que histológicamente se caracterizaban por foliculotropismo y grados variables de depósitos de mucina.
DESCRIPCIÓN DE LOS CASOS
Caso 1Una mujer de 40 años acudió a la consulta refiriendo una historia de 2 años de evolución de placas eritematosas y descamativas generalizadas asociadas a lesiones papulosas de pequeño tamaño. En los últimos 6 meses había perdido la mayor parte del pelo corporal. En la exploración física presentaba numerosas pápulas puntiformes queratósicas foliculares localizadas en tronco y extremidades (fig. 1). Se observaba también alopecia difusa no cicatrizal generalizada con numerosas espículas foliculares. En la cara se apreciaban lesiones quísticas agrupadas, cubiertas por piel de aspecto normal, que habían aparecido en el último mes. Presentaba también queratodermia palmoplantar, y se palpaban adenopatías generalizadas.
Varias biopsias cutáneas tomadas de distintas localizaciones presentaban, como característica común, la presencia de densos infiltrados linfocitarios dérmicos constituidos por células de tamaño pequeño-interme-dio con núcleos hipercromáticos y cerebriformes con marcada tendencia a la distribución perifolicular y ocasionales linfocitos que infiltraban el epitelio folicular (fig. 2). Algunos folículos se acompañaban de mucinosis folicular (fig. 3). Destacaba la presencia de densos infiltrados linfocitarios, semejantes a los perifoliculares, que se localizaban en íntimo contacto con los ovillos ecrinos con infiltración ocasional del epitelio ductal (fig. 4).
Fig. 1.— Caso 1. Pápulas puntiformes queratósicas foliculares.
Fig. 2.—Infiltrado linfoide atípico en el interior de un folículo piloso. (Hematoxilina-eosina, ×200.)
Fig. 3.—Detalle de la mucinosis folicular. (Azul Alcián pH 2,5, ×200.)
Fig. 4.—Marcados infiltrados linfocitarios alrededor del ovillo ecrino. (Hematoxilina-eosina, ×100.)
El estudio analítico, incluyendo sistemático de sangre, bioquímica, coagulación y cuantificación de inmunoglobulinas estaba dentro de los parámetros normales. Se realizó una tomografía computarizada cervicotoracoabdominal que reveló múltiples adenopatías cervicales, supraclaviculares, submandibulares y axilares bilaterales de 1,5 a 2 cm de diámetro. La biopsia de un ganglio puso de manifiesto una infiltración específica linfomatosa por células CD3+ y CD43+. La biopsia de médula ósea no reveló infiltración específica. El estudio de genética molecular demostró reordenamiento clonal del gen del receptor de células T (TCR-) en la piel y en el ganglio linfático.
La paciente recibió tratamiento inicialmente con carmustina (BCNU) y quimioterapia sistémica con ciclofosfamida, adriamicina, vincristina y prednisona (CHOP) con escasa respuesta y posteriormente con etopósido, metilprednisolona, citarabina y cisplatino (ESHAP), con una reducción en el tamaño de las adenopatías. Aproximadamente 2 meses después, debido a la progresión de la enfermedad a nivel cutáneo, recibió tratamiento con baño de electrones e interferón alfa (IFN-), con el cual sólo se consiguió una mejoría parcial. Un año después del diagnóstico, la paciente presentó un aumento del tamaño de ambas parótidas y la biopsia reveló infiltración por linfoma de células T periféricas. La biopsia de médula ósea en ese momento no presentaba signos de infiltración tumoral. Un mes después la paciente falleció por fracaso multiorgánico. No se realizó autopsia porque la familia se negó.
Caso 2Un varón de 67 años refería la aparición, 10 años antes del momento de la consulta, de placas eritema-tosas de aproximadamente 10 × 10 cm de diámetro, bien delimitadas, de superficie abollonada, en las que se apreciaban numerosos quistes y comedones y que habían aumentado de forma progresiva de tamaño. Estas placas eran intensamente pruriginosas y se localizaban en la región frontal derecha y en la espalda (fig. 5). Asimismo presentaba placas eritematosas descamativas, discretamente infiltradas, localizadas en la espalda, ingles y antebrazos. No se palpaban adenopatías ni visceromegalias.
Fig. 5.— Caso 2. En el lado derecho de la espalda se observa una placa eritematosa bien delimitada de superficie abollonada en las que se apreciaban numerosos quistes y comedones.
Los hallazgos histológicos de las lesiones foliculares con quistes y comedones fueron similares a los descritos en el caso 1. Además, mostraba en algunas biopsias la presencia de una marcada dilatación folicular y la presencia de afectación epidérmica de tipo micosis fungoide en placas en otras.
El estudio de extensión incluyó analítica con sistemático de sangre, bioquímica, cuantificación de inmunoglobulinas, determinación de 2-microglobulina y lactato deshidrogenasa, serologías de virus de la hepatitis B y C, varicela-zóster, de Epstein-Barr y del herpes simple, inmunofenotipo, reacción de Mantoux y radiografía de tórax, siendo todos los resultados normales. El reordenamiento en sangre periférica resultó negativo para el gen del TCR-.
El paciente comenzó tratamiento con psoraleno y luz ultravioleta (PUVA), a razón de tres sesiones por semana (Oxsoralén 0,6 mg/kg y UVA alcanzando una dosis máxima de 10 J/cm2 por sesión) e IFN- en dosis de 9 millones subcutáneos tres veces a la semana, con respuesta parcial. En la actualidad el paciente sigue con este tratamiento iniciado hace 16 meses y en ningún momento se ha visto libre de lesiones, alcanzando sólo respuestas parciales.
DISCUSIÓN
La micosis fungoide folicular es una variante poco frecuente de micosis fungoide en la cual los linfocitos atípicos infiltran y rodean los folículos pilosos (foliculotropismo) determinando una presentación clínica bien definida, con aparición de comedones, quistes, hiperqueratosis folicular, alopecia, hiperqueratosis palmoplantar y, ocasionalmente, placas de micosis fungoide clásica, aunque no todos los pacientes presentan todas estas alteraciones. Nuestros pacientes presentaban una sintomatología característica de micosis fungoide folicular con quistes, comedones, lesiones foliculares y alopecia no cicatrizal con intenso prurito. La localización de estas lesiones en la cara y el cuello se ha considerado característica4,5 . Estas lesiones pueden constituir la única manifestación clínica de la enfermedad, como en el primer caso, o presentar también lesiones de micosis fungoide clásica, como en el segundo caso.
Desde el punto de vista anatomopatológico, el dato característico es la presencia de un infiltrado linfocítico atípico que rodea e infiltra la pared de los folículos pilosos. Este infiltrado produciría cambios foliculares como dilatación, formación de quistes y comedones. No existe una definición tipificada de la micosis fungoide folicular y la presencia o ausencia de mucina ha sido motivo de debate. Mientras que algunos autores consideran que la micosis fungoide folicular se caracteriza por la ausencia de epidermotropismo o mucinosis folicular6-10 , se han descrito casos en los que la presencia de depósitos de intensidad variable de mucina es un hallazgo asocia-4,11-15 , incluyendo uno de los primeros casos que sirvieron para acuñar este término5 . Existen autores que defienden la existencia de dos entidades distin-9,10 ; por un lado, la micosis fungoide folicular, que sería una variante rara de linfoma cutáneo de células T caracterizada por la presencia de infiltrados de linfocitos CD4+ atípicos alrededor y en el epitelio de los folículos pilosos, y, por otro lado, la mucinosis folicular asociada con micosis fungoide, caracterizada por la presencia de depósitos de mucina en el epitelio folicular, además de un infiltrado polimorfo de linfocitos y eosinófilos perivascular superficial y profundo más intenso alrededor de los folículos pilosos. Sin embargo, esta separación parece artificial, ya que entre los dos extremos descritos existe un espectro de pacientes que presentan grados variables de depósitos de mucina y de afectación epidérmica. Van Doorn et al4 realizaron un estudio de 51 pacientes con características clinicopatológicas de micosis fungoide folicular. Todos los pacientes, excepto dos, presentaban depósitos de mucina folicular en grado variable asociados a foliculotropismo. El número de linfocitos atípicos que infiltraban el folículo no se correlacionaba con la cantidad de mucina depositada. La afectación epidérmica puede también encontrarse en los casos de micosis fungoide folicular, aunque por lo general es de poca intensidad. En el estudio de Van Doorn et al4 , 5 de los 51 pacientes presentaban tanto epidermotropismo como foliculotropismo. No se incluyeron en el estudio 3 pacientes con historia de micosis fungoide clásica que desarrollaron lesiones de micosis fungoide folicular.
Histológicamente, los 2 pacientes descritos en este trabajo casos presentaban foliculotropismo y los depósitos de mucina estaban presentes en mayor o menor grado. La paciente del primer caso presentaba siringotropismo en las cinco biopsias realizadas. La afectación de las glándulas ecrinas en forma de siringotropismo en pacientes con micosis fungoide folicular no es frecuente4,16,17 .
En cuanto a la evolución de la enfermedad, se ha descrito una mala respuesta al tratamiento con mal pronóstico. Algunos autores equiparan el tipo folicular al estadio tumoral de la variante clásica4 . El grupo de estudio de linfomas de la EORTC propone la radioterapia con baño de electrones como el tratamiento de elección en los casos de micosis fungoide folicular con o sin mucina1 .
En nuestra opinión la micosis fungoide folicular se presenta como un espectro clínico en el que pueden predominar una u otra lesión clínica, desde lesiones foliculares hasta quistes o comedones, localizados predominantemente en cabeza y cuello y con hallazgos histológicos de infiltrado atípico fundamentalmente perifolicular e intrafolicular. La presencia de epidermotropismo asociado es variable y no debe condicionar el diagnóstico. La presencia de mucina tampoco es un hecho constante y se trata probablemente de un hallazgo de carácter reactivo e inespecífico. Por lo tanto, el depósito de mucina no debe descartar el diagnóstico de micosis fungoide folicular.
Correspondencia:
Diana Ruiz-Genao. Servicio de Dermatología. Hospital Universitario de La Princesa. Diego de León, 62. 28006 Madrid. España. diana@aedv.es
Recibido el 1 de septiembre de 2004. Aceptado el 28 de diciembre de 2004.